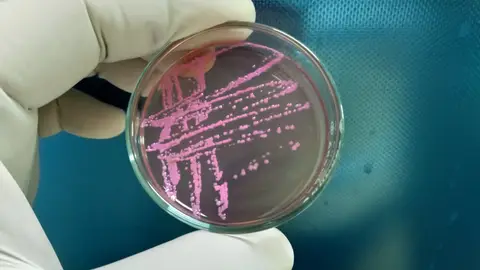

TE LO CONTAMOS
Shigella, así es la bacteria que casi mata a Ángel Llàcer: síntomas y cómo se contagia
El actor contrajo la infección en Vietnam y ha tenido que pasar dos veces por quirófano.
Publicidad
Ángel Llàcer, el conocido actor y director de televisión, está atravesando uno de los peores momentos de su vida después de que una infección casi le provoca la muerte.
Tras meses alejado de los medios, Llácer ha reaparecido para contar la terrible experiencia que comenzó con un viaje a Vietnam. Allí, se contagió de una peligrosa bacteria llamada Shigella, una infección que se transmite al ingerir comida o agua contaminadas por las heces de una persona contagiada o por contacto directo con un infectado.
Tal y como ha contado, su situación llegó a ser tan grave que los médicos le recomendaron que se despidiese de su familia. Afortunadamente, podrá seguir disfrutando de los suyos, aunque todavía necesita mucha rehabilitación y recuperación por las secuelas que le ha dejado esta bacteria.
Qué es la bacteria Shigella
La Shigella es un género de bacterias que causa shigelosis, una infección intestinal caracterizada por diarrea, fiebre y dolor abdominal. La shigelosis se transmite principalmente a través de la ruta fecal-oral, lo que significa que puede propagarse por el consumo de alimentos o agua contaminados, así como por contacto directo con personas infectadas.
Síntomas
Los síntomas de una infección por Shigella suelen aparecer entre 1 a 3 días después de la exposición e incluyen:
- Diarrea (a menudo, con sangre o mucosidad)
- Dolor o calambres estomacales
- Fiebre
- Náuseas o vómitos
En el caso de Ángel Llácer se encontraba de vacaciones en Vietnam cuando comenzó a encontrarse mal. Cree que la intoxicación alimentaria se la provocaron o unos caracoles o anchoas que comió. Pero es solo su suposición. Es imposible saberlo con seguridad.
En su caso, además de los síntomas típicos, pasó tres días en cama vomitando. Después, parecía que todo había acabado, pero desgraciadamente no había hecho más que empezar.
A pesar de que se trata de una enfermedad conocida en Europa, el impacto de esta enfermedad es muy bajo. Sin embargo, el contagio tanto de bacterias como de otros microorganismos cuando se viaja a países exóticos es habitual. Por ello, debemos ir con mucho cuidado.
Publicidad